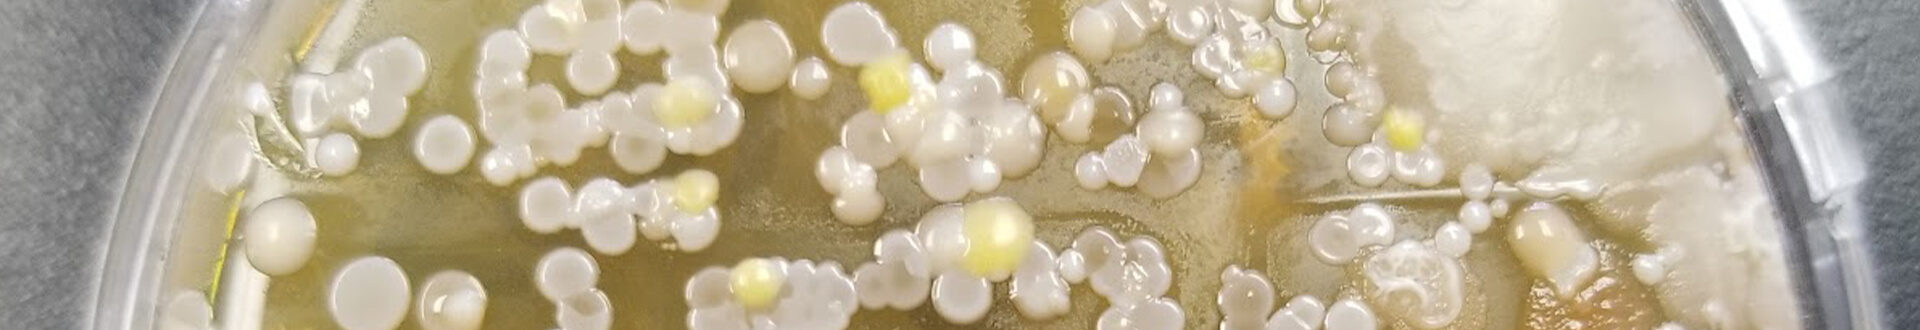

From Computer Scientists to Laboratory Scientists
Within the last year or so of sharing an office space with Azzur Labs I have learned quite a bit about bacteria. Turns out sponges, steering wheels, and cell phones are all notoriously more disgusting than you could ever imagine. State Food Safety actually declares that cell phones have 25,107 bacteria per square inch. If you’re not already cleaning your phone after hearing that statistic, you should be. If you’re reading this on your phone, please take a break and wipe it down before continuing. I promise you won’t regret it.
One of their employees actually suggested that I should change out my kitchen sponge after just a couple of days! Could you imagine how much money I would be spending on sponges in one year? Okay, I was curious and actually did the math. You can buy a pack of 6 sponges from Amazon for $5.49. If I changed my sponge every 2 days, that means I would be spending about $168 a year! I don’t know about you, but personally, I’d rather spend that on tacos and pizza.
When you share an office space with a lab, it’s only natural to want to conduct an experiment or two. After hearing experts rant about how nasty an item that spends the majority of its time covered in soap can be, I became increasingly curious about our everyday devices that coincidentally are not covered in soap, but rather in pizza grease, makeup, and lord knows what other kinds of gunk.
In the world of digital marketing, our technology is our lifeline. I strategically chose items around the office that I know aren’t cleaned as often as they should or are used so frequently that no amount of disinfectant could get them clean. So, without further ado, here are the results ranked from least likely to make you vomit, to most.
I am well-known for a streaky monitor that rarely gets wiped down. My philosophy is, “Why clean something that you’re just going to get dirty again two seconds later?” On a side note, I have the same feeling about making the bed in the morning. Surprisingly, there was little to no bacteria on my monitor! Now, I know what you’re thinking. I sabotaged the whole experiment because I didn't want to come across as the dirty one in the office… I’m here to tell you that you’re wrong. I thought for sure my monitor would be caked in all sorts of nastiness. There is a good chance I didn’t press the dish down hard enough while doing the experiment. After all, I am not a real scientist.
You would be hard-pressed to find Jerald anywhere without his iPad. Considering the fact that his iPad is not only used around the office for user testing, but it is also his personal device, I was very surprised to see how clean it was! Does Jerald live his life between four sterile white walls?! Even if he does, how does that explain how clean it is after multiple people around the office put their grubby hands all over it for usability testing any time we launch a new website or application? I have a good feeling Jerald wiped this sucker down a couple days before I did the test because I was blown away by how clean it was. If not, hats off to him for having one of the cleanest devices around the office!
This one should come as no surprise. Don’t forget that experts have already identified that cell phones are quite possibly the one device that should be cleaned more than all the others combined. On top of that, Hillary has already written a blog about her struggle to unplug for 24 hours, so I was not surprised to see the amount of bacteria on her phone. However, it did surprise me that two other items I tested had MORE bacteria than a phone that comes in contact with food particles daily, falls on the floor more often than any phone should, gets shoved into pockets, and pressed up against a human’s face more times in one day than the average cell phone.
I’m not trying to say that Josh’s desk is typically a breeding ground for bacteria, but I do think that bacteria could find some attractive qualities about it. That being said, I think this was the most surprising result for the sole reason that Hillary had disinfected Josh’s desk just the day before (I didn’t know this until after I had already collected the sample). In Josh’s defense, he was sick the week that I conducted this experiment. After seeing the results, please dear lord stay home when you are sick. No one, and I mean NO ONE, wants you sneezing this kind of vile bacteria all over the office. Work from home, eat some soup and keep the sickness to yourself.
EW! You can LITERALLY see the outline of the keys. To be fair, our keyboards are likely used more than our phones on a daily basis. On busy days, we even eat at our desks and work simultaneously so I can only imagine that this is mostly caused by food particles. I’m still holding down some bile while reflecting on the number of times I have used my co-workers’ keyboards. When we find ourselves in a pickle and reach out for help, it’s pretty normal to have a co-worker take over our keyboard and mouse to help resolve the issue. Needless to say, I will think twice before touching any of their keyboards again!
This whole experiment started as something fun to write about, but it has ended as a huge eye-opener. I used to think that we were all relatively clean people, but apparently, we could be doing better. Personally, I have washed my hands more, cleaned my devices more, and have been more hesitant to touch literally everything after this experiment. I hope you vow to do the same!
One of their employees actually suggested that I should change out my kitchen sponge after just a couple of days! Could you imagine how much money I would be spending on sponges in one year? Okay, I was curious and actually did the math. You can buy a pack of 6 sponges from Amazon for $5.49. If I changed my sponge every 2 days, that means I would be spending about $168 a year! I don’t know about you, but personally, I’d rather spend that on tacos and pizza.
When you share an office space with a lab, it’s only natural to want to conduct an experiment or two. After hearing experts rant about how nasty an item that spends the majority of its time covered in soap can be, I became increasingly curious about our everyday devices that coincidentally are not covered in soap, but rather in pizza grease, makeup, and lord knows what other kinds of gunk.
In the world of digital marketing, our technology is our lifeline. I strategically chose items around the office that I know aren’t cleaned as often as they should or are used so frequently that no amount of disinfectant could get them clean. So, without further ado, here are the results ranked from least likely to make you vomit, to most.
 My Computer Monitor
My Computer Monitor
I am well-known for a streaky monitor that rarely gets wiped down. My philosophy is, “Why clean something that you’re just going to get dirty again two seconds later?” On a side note, I have the same feeling about making the bed in the morning. Surprisingly, there was little to no bacteria on my monitor! Now, I know what you’re thinking. I sabotaged the whole experiment because I didn't want to come across as the dirty one in the office… I’m here to tell you that you’re wrong. I thought for sure my monitor would be caked in all sorts of nastiness. There is a good chance I didn’t press the dish down hard enough while doing the experiment. After all, I am not a real scientist.
 Jeralds’ iPad
Jeralds’ iPad
You would be hard-pressed to find Jerald anywhere without his iPad. Considering the fact that his iPad is not only used around the office for user testing, but it is also his personal device, I was very surprised to see how clean it was! Does Jerald live his life between four sterile white walls?! Even if he does, how does that explain how clean it is after multiple people around the office put their grubby hands all over it for usability testing any time we launch a new website or application? I have a good feeling Jerald wiped this sucker down a couple days before I did the test because I was blown away by how clean it was. If not, hats off to him for having one of the cleanest devices around the office!
 Hillary’s Cellphone
Hillary’s Cellphone
This one should come as no surprise. Don’t forget that experts have already identified that cell phones are quite possibly the one device that should be cleaned more than all the others combined. On top of that, Hillary has already written a blog about her struggle to unplug for 24 hours, so I was not surprised to see the amount of bacteria on her phone. However, it did surprise me that two other items I tested had MORE bacteria than a phone that comes in contact with food particles daily, falls on the floor more often than any phone should, gets shoved into pockets, and pressed up against a human’s face more times in one day than the average cell phone.
 Josh’s Desk
Josh’s Desk
I’m not trying to say that Josh’s desk is typically a breeding ground for bacteria, but I do think that bacteria could find some attractive qualities about it. That being said, I think this was the most surprising result for the sole reason that Hillary had disinfected Josh’s desk just the day before (I didn’t know this until after I had already collected the sample). In Josh’s defense, he was sick the week that I conducted this experiment. After seeing the results, please dear lord stay home when you are sick. No one, and I mean NO ONE, wants you sneezing this kind of vile bacteria all over the office. Work from home, eat some soup and keep the sickness to yourself.
 Angie’s Keyboard
Angie’s Keyboard
EW! You can LITERALLY see the outline of the keys. To be fair, our keyboards are likely used more than our phones on a daily basis. On busy days, we even eat at our desks and work simultaneously so I can only imagine that this is mostly caused by food particles. I’m still holding down some bile while reflecting on the number of times I have used my co-workers’ keyboards. When we find ourselves in a pickle and reach out for help, it’s pretty normal to have a co-worker take over our keyboard and mouse to help resolve the issue. Needless to say, I will think twice before touching any of their keyboards again!This whole experiment started as something fun to write about, but it has ended as a huge eye-opener. I used to think that we were all relatively clean people, but apparently, we could be doing better. Personally, I have washed my hands more, cleaned my devices more, and have been more hesitant to touch literally everything after this experiment. I hope you vow to do the same!